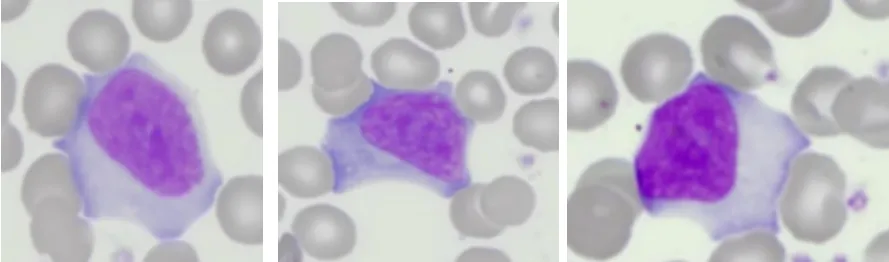
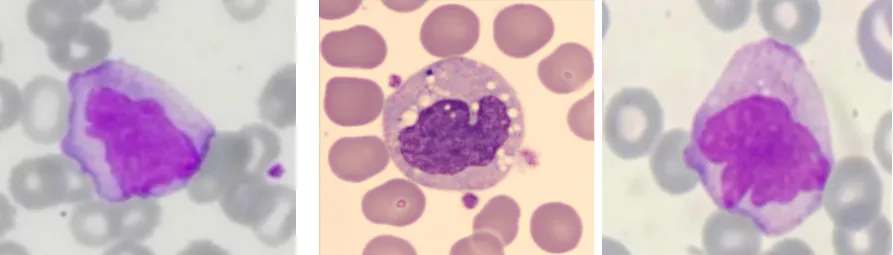

Diferenciação entre Linfócito Reativo e Monócito: Como Reconhecer ?
Diferenciar Linfócito Reativo de Monócito em análises laboratoriais pode ser um desafio para analistas clínicos. No entanto, é crucial reconhecer essas células adequadamente para um diagnóstico preciso.
Por isso, neste artigo, abordaremos as características distintas de ambas as células bem como como diferenciá-las de forma eficaz em sua rotina profissional.
Linfócito Reativo: Visão Geral e Importância do Reconhecimento
Os linfócitos reativos, por sua vez, são linfócitos com alterações morfológicas benignas, desencadeadas por estímulos imunológicos, especialmente em processos inflamatórios ou infecciosos, como os de origem viral.
Dessa forma, é fundamental identificar essas células, pois, além disso, suas alterações morfológicas e o aumento em quantidade podem indicar uma resposta imunológica ativa.

Morfologia do Linfócito Reativo:
– Podem ter tamanho aumentado;
– Contorno nuclear irregular;
– Cromatina com regiões mais frouxas;
– Presença ou não de nucléolos;
– Citoplasma limpo com basofilia variável, podendo conter vacúolos e variações de cores;
Ao se deparar com células adjacentes, como hemácias, o linfócito reativo respeita o espaço ao contorná-las na maioria das vezes.
Monócito: Características e Identificação
Os Monócitos, por outro lado, são as maiores células de defesa presentes no sangue periférico. Seu núcleo é geralmente reniforme, no entanto, pode apresentar grande variabilidade morfológica.
Além disso, o citoplasma tem uma coloração cinza-azulada opaca, podendo conter vacúolos e grânulos azurófilos finos (aspecto sujo). A cromatina é madura, porém, pode ter um aspecto um pouco mais frouxo que a dos outros leucócitos maduros.
Diferenciação entre Linfócito Reativo e Monócito
Para diferenciar eficientemente essas células, é essencial que o analista clínico observe atentamente as características do núcleo e do citoplasma. Ademais, nunca se deve considerar apenas uma característica isolada, sendo crucial correlacionar os achados laboratoriais com a história clínica do paciente.
Conclusão
Portanto, o conhecimento preciso na diferenciação entre Linfócito Reativo e Monócito é um aspecto vital para o diagnóstico adequado de pacientes. Afinal, a compreensão das características morfológicas dessas células e sua correta identificação ajudarão a proporcionar um atendimento clínico mais eficaz e preciso.
O próximo passo de todo analista que deseja ter mais segurança na bancada
Todo analista que busca se destacar e se tornar um profissional mais atualizado, capacitado e qualificado para o mercado de trabalho precisa considerar uma pós-graduação.
Um profissional com especialização é valorizado na área laboratorial; esse é um fato inegável.
Unimos o útil ao agradável ao desenvolver uma pós-graduação em Hematologia Laboratorial e Clínica.
Para aqueles que procuram a comodidade de uma pós-graduação 100% online e ao vivo, sem abrir mão da excelência no ensino, temos a solução ideal.
Nossa metodologia combina teoria e prática da rotina laboratorial, garantindo um aprendizado efetivo.
Contamos com um corpo docente altamente qualificado, com os melhores professores do Brasil, referências em suas áreas de atuação.
No Instituto Nacional de Medicina Laboratorial, temos apenas um objetivo: mais do que ensinar, vamos tornar VOCÊ uma referência.
Toque no botão abaixo e conheça a pós-graduação em Hematologia Laboratorial e Clínica.
QUERO CONHECER TODOS OS DETALHES DA PÓS-GRADUAÇÃO
Referências:
Bain, Barbara J. Células sanguíneas : um guia prático [recurso eletrônico] / Barbara J. Bain ; [tradução: Renato Failace]. – 5. ed. – Porto Alegre : Artmed, 2016.
Oliveira, Raimundo. Atlas de Hematologia. – 1.ed. – São Paulo: Livraria Médica Paulista Editora, 2014.



